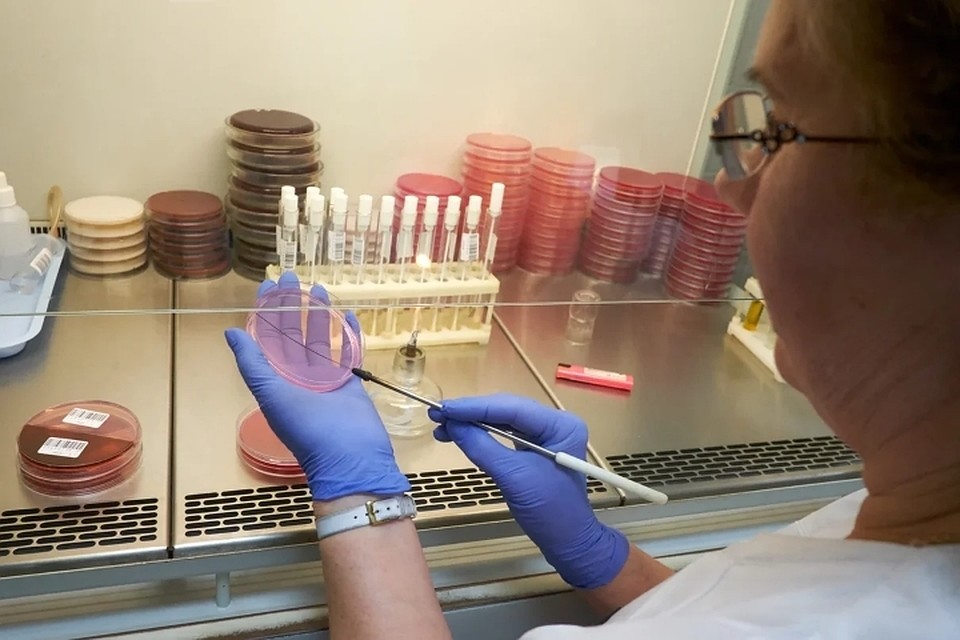

Кп Ру Гороскоп На апрель 2022

⚡ 👉🏻👉🏻👉🏻 ИНФОРМАЦИЯ ДОСТУПНА ЗДЕСЬ ЖМИТЕ 👈🏻👈🏻👈🏻
Ба Цзы для начинающих
Уникальный комплексный курс
24 МАЯ 2021
Базовый курс для тех, кто хочет знать бацзы глубоко, хорошо понимать причинно-следственные связи в карте, практиковать или консультировать!
Вы научитесь влиять на важные сферы своей жизни. Прогнозировать развитие событий и корректировать направления их развития.
Рекомендуемый срок изучения 3 месяца
17 уроков по 2-2.5 часа+онлайн занятия 2 раза в месяц
Онлайн практика по вашим картам дополнительно к урокам в записи
Закрытая группа бацзы с поддержкой бессрочно и онлайн встречи в группе
Ба Цзы - это древняя китайская наука, основанная на дате рождения человека и системы у-син.
Ба Цзы предлагает взглянуть на человека как на некий природный комплекс, который определяет характер и поступки человека, которые в итоге слагают его судьбу.
И есть "приходящий" климат, который либо помогает комплексу развиваться либо испытывает его на прочность.
Поэтому когда в позднем возрасте к человеку приходит "правильный" климат, неожиданно открываются способности и невольно думаешь - кто этот человек, которого мы раньше знали
Станет понятно - будет ли человек руководителем?
Будет ли иметь деньги или просто говорить о них в институте на кафедре финансов?
Кому полезно работать в хорошем офисе и носить брэндийную кепку.
А кому работать с ноутом в дороге на коленке...
Это не значит, что судьба это фатум.
Есть некий фактор "Х"- "нечто большее", которое всегда оставляет место загадке.
Но часто мы прикладываем усилия не в то время и не в те вещи и не с теми людьми.
В Ба цзы мы учимся выбирать и выбирать грамотно!
Узнаете секретные Фишки, которые работают вне зависимости от понимания силы и слабости карты, но которые можно использовать, чтобы добиться успеха гарантировано
Преодолеете страх чтения карты Ба Цзы. 100% научитесь находить полезное и оценивать течение ци в дате рождения.
Полезные божества: кто они? Как с ними договориться?) Небесные стволы или Земные ветви?Как это проявляется на уровне личности?
Характер человека. Его сильные и слабые стороны, таланты. На что можно опираться в разных сферах жизни.
Сможете найти ключик к любому человеку. А также понять какими людьми себя окружать, чтобы автоматически подключить вашу Удачу.
Научитесь прогнозировать основные события. Сможете скорректировать свое поведение, чтобы способствовать желательным событиям.
Любовь, брак, карьера, деньги и реализация заиграет для вас в новом свете. Это поможет определиться не только вам, но и вашем детям. На правильном ли вы пути?
Как за 2 минуты оценить «токсичность» вашего окружения, которое забирает и истощает нашу энергетику, приносит проблемы и неприятности?
1. Еженедельно вам открывается материал для изучения, который вы изучаетет в течение недели.
2. Раз в неделю мы встречаемся на онлайн занятиях, где я отвечаю на ваши вопросы и я веду практические занятия по вашим картам и домашним работам.
3. Материалы курса остаются у вас в бессрочном пользовании. Вы можете спокойно в любое время в удобной для вас обстановке повторно прослушать курс, если что то непонятно.
4. Вы добавляетесь в закрытую группу бацзы бессрочно.
5. Домашние задания высылаются на почту: yuliyatimoshenkova999@ya.ru
6. Вы также можете задавать вопросы и получать на них ответы и пояснения. Я всегда отвечу на них.
7. По окончанию курсапри успешном выполнении итоговой работы вам высылается СЕРТИФИКАТ о прохождении модуля
Для получения сертификата необходимо будет в течение 3 месяцев выслать итоговую работе на почту преподавателю.
Как можно применять бацзы всего за 3 недели
ПРОГРАММА КУРСА БАЦЗЫ ДЛЯ НАЧИНАЮЩИХ
Ци, Небо-земля-человек в жизни и в бацзы. Как это работает на практике?
Тайцзы: основа изменений и перемен, баланса в бацзы
У-син и течение Ци - основа чтения карты и событий в бацзы
- Пять элементов, пять трансформаций - основа всех процессов, проявление в человеке и природе
- Китайский календарь: концепция времени в китайской метафизики
- Небесные стволы и земные ветви как качество ци пространства
- Карта Ба Цзы - подходы к чтению баланса
- Небесные стволы в бацзы как качества чистой ци
- Полезные божества в карте бацзы для каждой дневной доминанты, как основа интерпретации
- Сезоны и климат карты. Рисуем картину природы.
- Сезонное регулирование НС как основа баланса карты: соединяем "полезные божества" и сезоны
- Пять божеств(социальных аспектов) в дате рождения, взаимоотношения между ними
- Как это влияет на человека и выбор направления в жизни.
- Что делать, если в карте нет денег? Что это значит? Если вы женщина? Чем регулируем
- Как восполнить ресурс, какие компании выбирать для работы?
- Что можно сказать о рабочем месте по карте бацзы?
- Читаем характер человека, его основные качества, ищем подход
- СНС как модели поведения, расширяем рычаги воздействия
- Бамбук бацзы, постоение СНС, ЗВ: Персики, Лошади и Хранилища
- Фазы ци как основа чтения карты: какого мужа искать, где работать, какое окружение создавать, лекартсва для низких фаз
- Дворцы как 4 столпа в Бацзы - глубокая интерпретация каждого
- Большое и малое тайцзы в дате рождения
- Характер, здоровье, периоды жизни, отношения с родителями, мужем, детьми, начальником, родителями, братьями и сестрами
- Можно ли заручиться поддержкой "Big босса"?
- Родственники в Ба Цзы и отношения с ними как НС в карте рождения
- Взаимодействие НС и ЗВ как основа чтения характера, отношений и событий
- НС: слияния и столкновения, условия трансформации
- ЗВ: слияния сезона, треугольников, парные, столкновения, наказания и самонаказание, тройное огненное и "наказание забияки"
- Сила и качество элемента в карте, как основа баланса и регулирования
- Умение читать течение ци в карте в отрыве от штампа "силы карты сила карты"
- Алгоритм определения полезных элементов
- Правила, которые работаю 100% всегда.
- 80% случаев не требует классического подсчета силы
- Устойчивость Господина дня и сила карты
- Полезность элементов: благоприятные и неблагоприятные элементы
- Оперативный и Отклоняемый элемент
- Полезные божества и сила карты - что первичнее?
- Сильный господин дня и сильная карта, сильный господин дня и слабая карта
- Какие практические вещи это несет? как влияет на характер и сферы жизни
- Символические звезды в бацзы: благородный человек, Вознаграждение 10 Небесных стволов, Лошадь Путешествий, Цветок Персика, Красный Луань, Звезда Академика, Звезды Одиночества и другие
- Свой бизнес или карьера? Что продавать? Стоит ли знакомить жену с друзьями? Какое рабочее место выбрать? Сложности в отношениях и многое и многое другое….
- Взаимодействие с домом брака и аспект мужчины в вашей дате рождения
- Типы личности: сильные и слабые стороны, выстраивание отношений, карьера, инвестиции, что нужно для успеха
- Как анализировать карту? С чего начать? Алгоритм действий
- Выбор профессии, учитываем стихии и божества
- Личная жизнь, отношения и брак - тематическое занятие
- Деньги, карьера, выбор сферы деятельности - тематическое занятие
- Здоровье в бацзы - тематическое занятие
Всего 17 тематических уроков по 2-2,5 часа +онлайн занятия 2 раза в месяц
Не надо верить – проверяйте. Убедитесь лично в том, что БаЦзы работает!
Юлия Тимошенкова - Консультант и Преподаватель Китайской Метафизики
Не читаю судьбу по дате рождения, а оптимизирую данные вашей “системы” с максимально эффективным для вас результатом
Доступ к курсу не имеет сроков. Он Ваш навсегда. Материалы курса вы скачиваете себе в личное пользование.
В любое удобное Вам время с любого носителя (компьютер, планшет, смартфон).
Как проходит практика на онлайн встречах?
Вы выполняете домашние задания и мы рассматриваем ваши карты на практических занятиях и обсуждаем в приватной группе
- Видео-уроки +практика - бессрочно у вас
- Методические материалы - бессрочно у вас
- Неогранниченный доступ к приватной группе бацзы
- Сертификат о прохождении модуля после итоговой работы
Стоимость курса составляет 18 000 рублей.
Вы может окончить его досочно при наличии времени, желания и возможности.
Оплата по месяцам - 6 000 рублей в месяц.
Если вы по каким либо причинам не сможетеучаствовать во 2 и 3 месяце, Вы можете взять паузу и присоединится к другой группе позднее. Набор ежемесячный.
17 уроков по 2-2,5 часа(лекции в записи) + 9 онлайн встреч ответы на вопросы и работа по вашим картам. 42 часа лекций+18 часов практики онлайн.
Итоговая работа+Сертификат+закрытая группа+разбор ваших карт преподавателем
Приобрести курс "Искусство Ба Цзы для начинающих" можно оставив заявку на участие в курсе.
На почту придет письмо о способах оплаты и подробностях работы. Если письмо не пришло - то необходимо добавить адрес yuliyatimoshenkova999@ya.ru в список желательных.
1. Переводом на карту Сбербанка по номеру карты или по номеру телефона (карта привязана к номеру):
3. Непосредственно сайте - нажав кнопку - "Оплатить курс" - через сервис Я. Кошелек. Не забудьте при этом указать вашу почту, Имя и телефон для связи.
4. Для международных систем Western Union, MoneyGram, Золотая корона и другие международные системы - Tver, Yuliya Timoshenkova
Если Вам удобен другой вариант оплаты, - свяжитесь с нами в мессенджере или по почте школы Юлии Тимошенковой: yuliyatimoshenkova999@ya.ru.
Ба Цзы для начинающих
Уникальный комплексный курс
24 МАЯ 2021
Базовый курс для тех, кто хочет знать бацзы глубоко, хорошо понимать причинно-следственные связи в карте, практиковать или консультировать!
Вы научитесь влиять на важные сферы своей жизни. Прогнозировать развитие событий и корректировать направления их развития.
Рекомендуемый срок изучения 3 месяца
17 уроков по 2-2.5 часа+онлайн занятия 2 раза в месяц
Онлайн практика по вашим картам дополнительно к урокам в записи
Закрытая группа бацзы с поддержкой бессрочно и онлайн встречи в группе
Ба Цзы - это древняя китайская наука, основанная на дате рождения человека и системы у-син.
Ба Цзы предлагает взглянуть на человека как на некий природный комплекс, который определяет характер и поступки человека, которые в итоге слагают его судьбу.
И есть "приходящий" климат, который либо помогает комплексу развиваться либо испытывает его на прочность.
Поэтому когда в позднем возрасте к человеку приходит "правильный" климат, неожиданно открываются способности и невольно думаешь - кто этот человек, которого мы раньше знали
Станет понятно - будет ли человек руководителем?
Будет ли иметь деньги или просто говорить о них в институте на кафедре финансов?
Кому полезно работать в хорошем офисе и носить брэндийную кепку.
А кому работать с ноутом в дороге на коленке...
Это не значит, что судьба это фатум.
Есть некий фактор "Х"- "нечто большее", которое всегда оставляет место загадке.
Но часто мы прикладываем усилия не в то время и не в те вещи и не с теми людьми.
В Ба цзы мы учимся выбирать и выбирать грамотно!
Узнаете секретные Фишки, которые работают вне зависимости от понимания силы и слабости карты, но которые можно использовать, чтобы добиться успеха гарантировано
Преодолеете страх чтения карты Ба Цзы. 100% научитесь находить полезное и оценивать течение ци в дате рождения.
Полезные божества: кто они? Как с ними договориться?) Небесные стволы или Земные ветви?Как это проявляется на уровне личности?
Характер человека. Его сильные и слабые стороны, таланты. На что можно опираться в разных сферах жизни.
Сможете найти ключик к любому человеку. А также понять какими людьми себя окружать, чтобы автоматически подключить вашу Удачу.
Научитесь прогнозировать основные события. Сможете скорректировать свое поведение, чтобы способствовать желательным событиям.
Любовь, брак, карьера, деньги и реализация заиграет для вас в новом свете. Это поможет определиться не только вам, но и вашем детям. На правильном ли вы пути?
Как за 2 минуты оценить «токсичность» вашего окружения, которое забирает и истощает нашу энергетику, приносит проблемы и неприятности?
1. Еженедельно вам открывается материал для изучения, который вы изучаетет в течение недели.
2. Раз в неделю мы встречаемся на онлайн занятиях, где я отвечаю на ваши вопросы и я веду практические занятия по вашим картам и домашним работам.
3. Материалы курса остаются у вас в бессрочном пользовании. Вы можете спокойно в любое время в удобной для вас обстановке повторно прослушать курс, если что то непонятно.
4. Вы добавляетесь в закрытую группу бацзы бессрочно.
5. Домашние задания высылаются на почту: yuliyatimoshenkova999@ya.ru
6. Вы также можете задавать вопросы и получать на них ответы и пояснения. Я всегда отвечу на них.
7. По окончанию курсапри успешном выполнении итоговой работы вам высылается СЕРТИФИКАТ о прохождении модуля
Для получения сертификата необходимо будет в течение 3 месяцев выслать итоговую работе на почту преподавателю.
Как можно применять бацзы всего за 3 недели
ПРОГРАММА КУРСА БАЦЗЫ ДЛЯ НАЧИНАЮЩИХ
Ци, Небо-земля-человек в жизни и в бацзы. Как это работает на практике?
Тайцзы: основа изменений и перемен, баланса в бацзы
У-син и течение Ци - основа чтения карты и событий в бацзы
- Пять элементов, пять трансформаций - основа всех процессов, проявление в человеке и природе
- Китайский календарь: концепция времени в китайской метафизики
- Небесные стволы и земные ветви как качество ци пространства
- Карта Ба Цзы - подходы к чтению баланса
- Небесные стволы в бацзы как качества чистой ци
- Полезные божества в карте бацзы для каждой дневной доминанты, как основа интерпретации
- Сезоны и климат карты. Рисуем картину природы.
- Сезонное регулирование НС как основа баланса карты: соединяем "полезные божества" и сезоны
- Пять божеств(социальных аспектов) в дате рождения, взаимоотношения между ними
- Как это влияет на человека и выбор направления в жизни.
- Что делать, если в карте нет денег? Что это значит? Если вы женщина? Чем регулируем
- Как восполнить ресурс, какие компании выбирать для работы?
- Что можно сказать о рабочем месте по карте бацзы?
- Читаем характер человека, его основные качества, ищем подход
- СНС как модели поведения, расширяем рычаги воздействия
- Бамбук бацзы, постоение СНС, ЗВ: Персики, Лошади и Хранилища
- Фазы ци как основа чтения карты: какого мужа искать, где работать, какое окружение создавать, лекартсва для низких фаз
- Дворцы как 4 столпа в Бацзы - глубокая интерпретация каждого
- Большое и малое тайцзы в дате рождения
- Характер, здоровье, периоды жизни, отношения с родителями, мужем, детьми, начальником, родителями, братьями и сестрами
- Можно ли заручиться поддержкой "Big босса"?
- Родственники в Ба Цзы и отношения с ними как НС в карте рождения
- Взаимодействие НС и ЗВ как основа чтения характера, отношений и событий
- НС: слияния и столкновения, условия трансформации
- ЗВ: слияния сезона, треугольников, парные, столкновения, наказания и самонаказание, тройное огненное и "наказание забияки"
- Сила и качество элемента в карте, как основа баланса и регулирования
- Умение читать течение ци в карте в отрыве от штампа "силы карты сила карты"
- Алгоритм определения полезных элементов
- Правила, которые работаю 100% всегда.
- 80% случаев не требует классического подсчета силы
- Устойчивость Господина дня и сила карты
- Полезность элементов: благоприятные и неблагоприятные элементы
- Оперативный и Отклоняемый элемент
- Полезные божества и сила карты - что первичнее?
- Сильный господин дня и сильная карта, сильный господин дня и слабая карта
- Какие практические вещи это несет? как влияет на характер и сферы жизни
- Символические звезды в бацзы: благородный человек, Вознаграждение 10 Небесных стволов, Лошадь Путешествий, Цветок Персика, Красный Луань, Звезда Академика, Звезды Одиночества и другие
- Свой бизнес или карьера? Что продавать? Стоит ли знакомить жену с друзьями? Какое рабочее место выбрать? Сложности в отношениях и многое и многое другое….
- Взаимодействие с домом брака и аспект мужчины в вашей дате рождения
- Типы личности: сильные и слабые стороны, выстраивание отношений, карьера, инвестиции, что нужно для успеха
- Как анализировать карту? С чего начать? Алгоритм действий
- Выбор профессии, учитываем стихии и божества
- Личная жизнь, отношения и брак - тематическое занятие
- Деньги, карьера, выбор сферы деятельности - тематическое занятие
- Здоровье в бацзы - тематическое занятие
Всего 17 тематических уроков по 2-2,5 часа +онлайн занятия 2 раза в месяц
Не надо верить – проверяйте. Убедитесь лично в том, что БаЦзы работает!
Юлия Тимошенкова - Консультант и Преподаватель Китайской Метафизики
Не читаю судьбу по дате рождения, а оптимизирую данные вашей “системы” с максимально эффективным для вас результатом
Доступ к курсу не имеет сроков. Он Ваш навсегда. Материалы курса вы скачиваете себе в личное пользование.
В любое удобное Вам время с любого носителя (компьютер, планшет, смартфон).
Как проходит практика на онлайн встречах?
Вы выполняете домашние задания и мы рассматриваем ваши карты на практических занятиях и обсуждаем в приватной группе
- Видео-уроки +практика - бессрочно у вас
- Методические материалы - бессрочно у вас
- Неогранниченный доступ к приватной группе бацзы
- Сертификат о прохождении модуля после итоговой работы
Стоимость курса составляет 18 000 рублей.
Вы может окончить его досочно при наличии времени, желания и возможности.
Оплата по месяцам - 6 000 рублей в месяц.
Если вы по каким либо причинам не сможетеучаствовать во 2 и 3 месяце, Вы можете взять паузу и присоединится к другой группе позднее. Набор ежемесячный.
17 уроков по 2-2,5 часа(лекции в записи) + 9 онлайн встреч ответы на вопросы и работа по вашим картам. 42 часа лекций+18 часов практики онлайн.
Итоговая работа+Сертификат+закрытая группа+разбор ваших карт преподавателем
Приобрести курс "Искусство Ба Цзы для начинающих" можно оставив заявку на участие в курсе.
На почту придет письмо о способах оплаты и подробностях работы. Если письмо не пришло - то необходимо добавить адрес yuliyatimoshenkova999@ya.ru в список желательных.
1. Переводом на карту Сбербанка по номеру карты или по номеру телефона (карта привязана к номеру):
3. Непосредственно сайте - нажав кнопку - "Оплатить курс" - через сервис Я. Кошелек. Не забудьте при этом указать вашу почту, Имя и телефон для связи.
4. Для международных систем Western Union, MoneyGram, Золотая корона и другие международные системы - Tver, Yuliya Timoshenkova
Если Вам удобен другой вариант оплаты, - свяжитесь с нами в мессенджере или по почте школы Юлии Тимошенковой: yuliyatimoshenkova999@ya.ru.
Гороскоп На 2021 Рыбы Дети
Совместимость По Нумерологии Джули По
Гороскоп Овен Свинья апрель 2022
Гороскоп Рыба Дракон Женщина На 2021 Год
Натальный Солярный Гороскоп
Новости России. Комсомольская Правда в РФ …
Комсомольская Правда в ... - KP.RU
Комсомольская Правда в Ростове-на-Дону
Лунный календарь на апрель 2022 года. Фазы Луны, лунны…
Календарь на апрель 2022 года
Гороскоп на апрель 2021 Телец женщина: точный прогноз
Гороскоп на месяц: май, бесплатный астрологически…
Производственный календарь на 2022 год, утвержденный ...
Гороскоп на 2021 год
Гороскоп на апрель 2021 ... - AstroMeridian.Ru
Кп Ру Гороскоп На апрель 2022










-patriarkh-moskovskii-i-vseya-rusi-4.jpg)